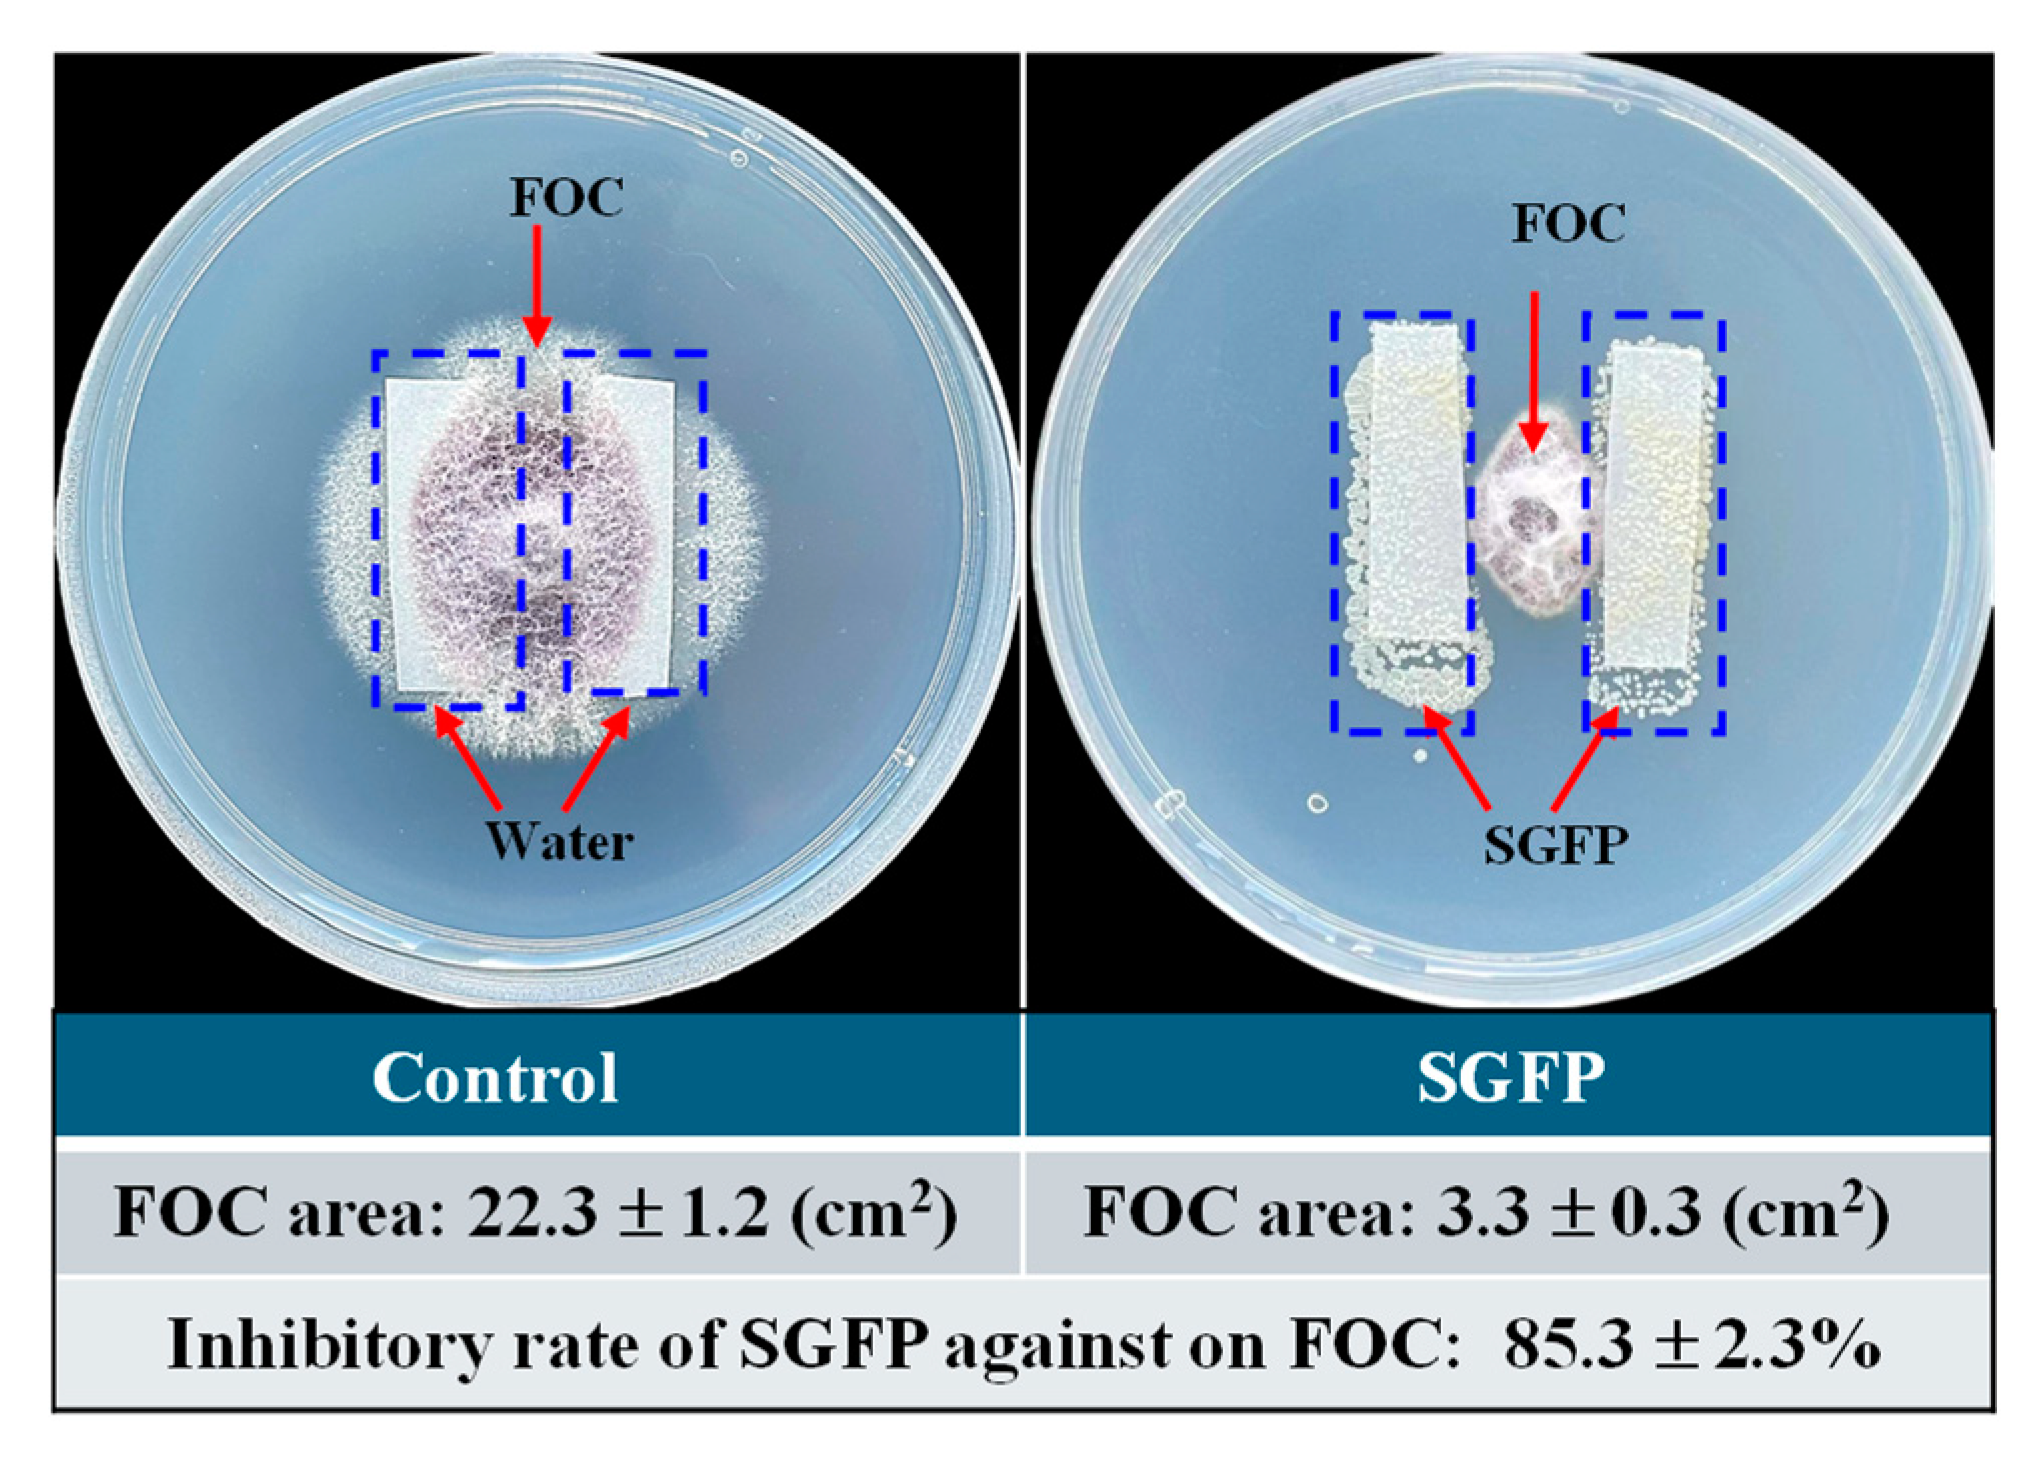
Jof 10 00885 g001

Potential of Streptomyces rochei G-6 for Biocontrol of Cucumber Wilt Disease and Growth Enhancement
Abstract
1. Introduction
2. Materials and Methods
2.1. Experimental Microorganisms and Their Maintenance, and SGFP Preparation
2.2. Inhibitory Effect of SGFP on FOC
2.3. Biocontrol Effect of SGFP Against Cucumber Wilt Disease and Its Growth Enhancement
2.3.1. Pot Cultivation and Experiment Design
2.3.2. Determination of Disease Incidence
2.3.3. Evaluation of Seedling Growth
2.3.4. Determination of Chlorophyll Content
2.3.5. Determination of Root Activity
2.4. Determination of Antioxidant Enzyme Activities and MDA Content
2.5. Determination of Nutrient Conversion Enzyme Activities in Soil
2.6. Statistical Analysis
3. Results and Discussion
3.1. Effect of SGFP on Inhibition of F. oxysporum Causing Plant Wilt Disease
3.2. Effect of SGFP on Preventing and Treating Cucumber Wilt Caused by FOC
3.3. Effect of SGFP on Enhancement of Cucumber Seedling Growth
3.4. Effect of SGFP on Antioxidant System of Cucumber Seedlings
3.5. Effect of SGFP on Nutrient Conversion in Soli
4. Conclusions
Author Contributions
Funding
Institutional Review Board Statement
Informed Consent Statement
Data Availability Statement
Acknowledgments
Conflicts of Interest
References
- Zhao, J.; Zhong, M.; Zhang, X.; Xue, C.; Zhang, C.; Ma, T.; Zhang, S. Suppression of Fusarium wilt of cucumber by ammonia gas fumigation via reduction of population in the field. Sci. Rep. 2017, 7, 43103. [Google Scholar] [CrossRef]
- Zhou, J.Y.; Wang, M.; Sun, Y.M.; Gu, Z.C.; Wang, R.R.; Saydin, A.; Shen, Q.R.; Guo, S.W. Nitrate increased cucumber tolerance to Fusarium wilt by regulating fungal toxin production and distribution. Toxins 2017, 9, 100. [Google Scholar] [CrossRef] [PubMed]
- Chang, C.; Fu, X.; Zhou, X.; Guo, M.; Wu, F. Effects of seven different companion plants on cucumber productivity, soil chemical characteristics and Pseudomonas community. J. Integr. Agric. 2017, 16, 2206–2214. [Google Scholar] [CrossRef]
- Sharma, D.; Shukla, A.; Gupta, M. Evaluation of bio-control agents against Fusarium wilt of cucumber. Int. J. Econ. Plants 2022, 9, 334–339. [Google Scholar] [CrossRef]
- Raza, W.; Ling, N.; Zhang, R.; Huang, Q.; Xu, Y.; Shen, Q. Success evaluation of the biological control of Fusarium wilts of cucumber, banana, and tomato since 2000 and future research strategies. Crit. Rev. Biotechnol. 2017, 37, 202–212. [Google Scholar] [CrossRef]
- Lian, H.; Li, R.; Ma, G.; Zhao, Z.; Zhang, T.; Li, M. The effect of Trichoderma harzianum agents on physiological-biochemical characteristics of cucumber and the control effect against Fusarium wilt. Sci. Rep. 2023, 13, 17606. [Google Scholar] [CrossRef]
- Ta, Y.; Fu, S.; Liu, H.; Zhang, C.; He, M.; Yu, H.; Ren, Y.; Han, Y.; Hu, W.; Yan, Z.; et al. Evaluation of Bacillus velezensis F9 for cucumber growth promotion and suppression of Fusarium wilt disease. Microorganisms 2024, 12, 1882. [Google Scholar] [CrossRef]
- Abbasi, S.; Safaie, N.; Sadeghi, A.; Shamsbakhsh, M. Streptomyces strains induce resistance to Fusarium oxysporum f. sp. lycopersici Race 3 in tomato through different molecular mechanisms. Front. Microbiol. 2019, 10, 1505. [Google Scholar] [CrossRef]
- Wang, S.; Liang, Y.; Shen, T.; Yang, H.; Shen, B. Biological characteristics of Streptomyces albospinus CT205 and its biocontrol potential against cucumber Fusarium wilt. Biocontrol. Sci. Technol. 2016, 26, 951–963. [Google Scholar] [CrossRef]
- Fu, R.; Cheng, R.; Wang, S.; Li, J.; Zhang, J. Succinoglycan Riclin reshaped the soil microbiota by accumulating plant probiotic species to improve the soil suppressiveness on Fusarium wilt of cucumber seedlings. Int. J. Biol. Macromol. 2021, 182, 1883–1892. [Google Scholar] [CrossRef]
- Dave, A.; Ingle, S. Streptomyces sp. S-9 promotes plant growth and confers resistance in Pigeon pea (Cajanus cajan) against Fusarium wilt. 3 Biotech 2021, 11, 459. [Google Scholar] [CrossRef]
- Peng, C.; An, D.; Ding, W.X.; Zhu, Y.X.; Ye, L.; Li, J. Fungichromin production by Streptomyces sp. WP-1, an endophyte from Pinus dabeshanensis, and its antifungal activity against Fusarium oxysporum. Appl. Microbiol. Biotechnol. 2020, 104, 10437–10449. [Google Scholar] [CrossRef] [PubMed]
- Tyc, O.; Song, C.; Dickschat, J.S.; Vos, M.; Garbeva, P. The ecological role of volatile and soluble secondary metabolites produced by soil bacteria. Trends Microbiol. 2017, 25, 280–292. [Google Scholar] [CrossRef]
- Velázquez-Herrera, F.D.; Lobo-Sánchez, M.; Carranza-Cuautle, G.M.; Sampieri, L.; Del Rocío Bustillos-Cristales, M.; Fetter, G. Novel bio-fertilizer based on nitrogen-fixing bacterium immobilized in a hydrotalcite/alginate composite material. Environ. Sci. Pollut. Res. 2022, 29, 32220–32226. [Google Scholar] [CrossRef]
- Cao, P.; Li, C.; Wang, H.; Yu, Z.; Xu, X.; Wang, X.; Zhao, J.; Xiang, W. Community structures and antifungal activity of root-associated endophytic actinobacteria in healthy and diseased cucumber plants and Streptomyces sp. HAAG3-15 as a promising biocontrol agent. Microorganisms 2020, 8, 236. [Google Scholar] [CrossRef] [PubMed]
- Le, K.D.; Kim, J.; Nguyen, H.T.; Yu, N.H.; Park, A.R.; Lee, C.W.; Kim, J.C. Streptomyces sp. JCK-6131 protects plants against bacterial and fungal diseases via two mechanisms. Front. Plant Sci. 2021, 12, 726266. [Google Scholar] [CrossRef] [PubMed]
- Kaur, T.; Rani, R.; Manhas, R.K. Biocontrol and plant growth promoting potential of phylogenetically new Streptomyces sp. MR14 of rhizospheric origin. AMB Express 2019, 9, 125. [Google Scholar] [CrossRef]
- El-Naggar, E.A.; El-Shweihy, N.M. Bioprocess development for L-asparaginase production by Streptomyces rochei, purification and in vitro efficacy against various human carcinoma cell lines. Sci. Rep. 2020, 10, 7942. [Google Scholar] [CrossRef]
- Ayoub, A.T.; Elrefaiy, M.A.; Arakawa, K. Computational prediction of the mode of binding of antitumor lankacidin C to tubulin. ACS Omega 2019, 4, 4461–4471. [Google Scholar] [CrossRef]
- Singla, D.K.; Johnson, T.A.; Dargani, Z.T. Exosome treatment enhances anti-inflammatory M2 macrophages and reduces inflammation-induced pyroptosis in doxorubicin-induced cardiomyopathy. Cells 2019, 8, 1224. [Google Scholar] [CrossRef] [PubMed]
- Kanini, G.S.; Katsifas, E.A.; Savvides, A.L.; Karagouni, A.D. Streptomyces rochei ACTA1551, an indigenous Greek isolate studied as a potential biocontrol agent against Fusarium oxysporum f. sp. lycopersici. Biomed. Res. Int. 2013, 2013, 387230. [Google Scholar] [CrossRef] [PubMed]
- Manish, S.; Rajesh, K.M. Purification and characterization of salvianolic acid B from Streptomyces sp.M4 possessing antifungal activity against fungal phytopathogens. Microbiol. Res. 2020, 237, 126478. [Google Scholar] [CrossRef]
- Abbasi, S.; Safaie, N.; Sadeghi, A.; Shamsbakhsh, M. Tissue-specific synergistic bio-priming of pepper by two Streptomyces species against Phytophthora capsici. PLoS ONE 2020, 15, e0230531. [Google Scholar] [CrossRef]
- Li, K.H.; Gao, Y.L.; Gao, M.Z.; Xiu, J.R.; Han, Y.Z.; Gao, C.; Dai, Y. A Strain of Streptomyces rochei as a Biocontrol Agent for the Control of Soilborne Wilt of Greenhouse Cucumber. China Patent CN114181873A, 14 January 2022. Available online: https://www.patentguru.com/cn/CN114181873B (accessed on 25 November 2024).
- Dong, X.M.; Lian, Q.G.; Chen, J.; Jia, R.M.; Zong, Z.F.; Ma, Q.; Wang, Y. The improved biocontrol agent, F1-35, protects watermelon against Fusarium wilt by triggering jasmonic acid and ethylene pathways. Microorganisms 2022, 10, 1710. [Google Scholar] [CrossRef]
- Chen, Y.; Tang, X.; Gao, X.; Zhang, B.; Luo, Y.; Yao, X. Antimicrobial property and photocatalytic antibacterial mechanism of the TiO2-doped SiO2 hybrid materials under ultraviolet-light irradiation and visible-light irradiation. Ceram Int. 2019, 45, 15505–15513. [Google Scholar] [CrossRef]
- Katsumata, S.; Toshima, H.; Hasegawa, M. Xylosylated detoxification of the rice flavonoid phytoalexin sakuranetin by the rice sheath blight fungus Rhizoctonia solani. Molecules 2018, 23, 276. [Google Scholar] [CrossRef]
- Xiong, J.; Tao, T.; Luo, Z.; Yan, S.; Liu, Y.; Yu, X.; Liu, G.; Xia, H.; Luo, L. RNA editing responses to oxidative stress between a wild abortive type male-sterile line and its maintainer line. Front. Plant Sci. 2017, 8, 2023. [Google Scholar] [CrossRef] [PubMed]
- Wang, X.K.; Huang, J.L. Principles and Techniques of Plant Physiological Biochemical Experiment; Higher Education Press: Beijing, China, 2015; pp. 123–125. [Google Scholar]
- Wang, W.; Liu, S.; Yan, M. Synthesis of γ-aminobutyric acid-modified chitooligosaccharide derivative and enhancing salt resistance of wheat seedlings. Molecules 2022, 27, 3068. [Google Scholar] [CrossRef]
- Dhindsa, R.S.; Plumb-Dhindsa, P.; Thorpe, T.A. Leaf senescence: Correlated with increased levels of membrane permeability and lipid peroxidation, and decreased levels of superoxide dismutase and catalase. J. Exp. Bot. 1981, 32, 93–101. [Google Scholar] [CrossRef]
- Rao, M.V.; Paliyath, G.; Ormrod, D.P. Ultraviolet-B-and ozone-induced biochemical changes in antioxidant enzymes of Arabidopsis thaliana. Plant Physiol. 1996, 110, 125–136. [Google Scholar] [CrossRef] [PubMed]
- Dhindsa, R.S.; Matowe, W. Drought tolerance in two mosses: Correlated with enzymatic defence against lipid peroxidation. J. Exp. Bot. 1981, 32, 79–91. [Google Scholar] [CrossRef]
- Guan, Y. Soil Enzyme and Its Study Method; Beijing China Agriculture Press: Beijing, China, 1986; pp. 274–297. [Google Scholar]
- Duncan, D. Multiple ranges and multiple “F” tests. Biometrics 1996, 11, 1–41. [Google Scholar] [CrossRef]
- Student. The probable error of a mean. Biometrika 1908, 6, 1–25. [Google Scholar] [CrossRef]
- Rambabu, V.; Suba, S.; Vijayakumar, S. Antimicrobial and antiproliferative prospective of kosinostatin–a secondary metabolite isolated from Streptomyces sp. J. Pharm. Anal. 2015, 5, 378–382. [Google Scholar] [CrossRef]
- Quinn, G.A.; Banat, A.M.; Abdelhameed, A.M.; Banat, I.M. Streptomyces from traditional medicine: Sources of new innovations in antibiotic discovery. J. Med. Microbiol. 2020, 69, 1040–1048. [Google Scholar] [CrossRef] [PubMed]
- Yi, J.S.; Kim, J.M.; Kang, M.K.; Kim, J.H.; Cho, H.S.; Ban, Y.H.; Song, M.C.; Son, K.H.; Yoon, Y.J. Whole-genome sequencing and analysis of Streptomyces strains producing multiple antinematode drugs. BMC Genom. 2022, 23, 610. [Google Scholar] [CrossRef] [PubMed]
- Le, K.D.; Yu, N.H.; Park, A.R.; Park, D.J.; Kim, C.-J.; Kim, J.C. Streptomyces sp. AN090126 as a biocontrol agent against bacterial and fungal plant diseases. Microorganisms 2022, 10, 791. [Google Scholar] [CrossRef]
- Qi, D.; Zou, L.; Zhou, D.; Chen, Y.; Gao, Z.; Feng, R.; Zhang, M.; Li, K.; Xie, J.; Wang, W. Taxonomy and broad-spectrum antifungal activity of Streptomyces sp. SCA3-4 isolated from rhizosphere soil of opuntia stricta. Front. Microbiol. 2019, 10, 1390. [Google Scholar] [CrossRef]
- Wang, X.; Du, Z.; Chen, C.; Guo, S.; Mao, Q.; Wu, W.; Wu, R.; Han, W.; Xie, P.; Zeng, Y.; et al. Antifungal effects and biocontrol potential of lipopeptide-producing Streptomyces against banana Fusarium wilt fungus Fusarium oxysporum f. sp. cubense. Front. Microbiol. 2023, 14, 1177393. [Google Scholar] [CrossRef]
- Kawicha, P.; Nitayaros, J.; Saman, P.; Thaporn, S.; Thanyasiriwat, T.; Somtrakoon, K.; Sangdee, K.; Sangdee, A. Evaluation of soil Streptomyces spp. for the biological control of Fusarium wilt disease and growth promotion in tomato and banana. Plant Pathol. J. 2023, 39, 108–122. [Google Scholar] [CrossRef]
- Lu, D.; Ma, Z.; Xu, X.; Yu, X. Isolation and identification of biocontrol agent Streptomyces rimosus M527 against Fusarium oxysporum f. sp. cucumerinum. J. Basic Microb. 2016, 56, 929–933. [Google Scholar] [CrossRef]
- Li, X.; Huang, P.; Wang, Q.; Xiao, L.; Liu, M.; Bolla, K.; Zhang, B.; Zheng, L.; Gan, B.; Liu, X.; et al. Staurosporine from the endophytic Streptomyces sp. strain CNS-42 acts as a potential biocontrol agent and growth elicitor in cucumber. Antonie Leeuwenhoek 2014, 106, 515–525. [Google Scholar] [CrossRef]
- Du, N.; Yang, Q.; Guo, H.; Xue, L.; Fu, R.; Dong, X.; Dong, H.; Guo, Z.; Zhang, T.; Piao, F.; et al. Dissection of Paenibacillus polymyxa NSY50-induced defense in cucumber roots against Fusarium oxysporum f. sp. cucumerinum by target metabolite profiling. Biology 2022, 11, 1028. [Google Scholar] [CrossRef] [PubMed]
- Li, Y.; Jiang, S.; Jiang, J.; Gao, C.; Qi, X.; Zhang, L.; Sun, S.; Dai, Y.; Fan, X. Synchronized efficacy and mechanism of alkaline fertilizer and biocontrol fungi for Fusarium oxysporum f. sp. cubense Tropical Race 4. J. Fungi 2022, 8, 261. [Google Scholar] [CrossRef]
- Jones, J.D.G.; Dangl, J.L. The plant immune system. Nature 2006, 444, 323–329. [Google Scholar] [CrossRef]
- Paolo, Z.; Jordi, S.; Loles, A.; Josep, P. Altered activities of extracellular soil enzymes by the interacting global environmental changes. Glob. Change Biol. 2023, 29, 2067–2091. [Google Scholar] [CrossRef]

| Treatment | Number of Seedlings | Disease Index | ||||
|---|---|---|---|---|---|---|
| Grade 0 | Grade 1 | Grade 2 | Grade 3 | Grade 4 | ||
| Cont | 30.0 ± 0.0 a | 0.0 ± 0.0 c | 0.0 ± 0.0 d | 0.0 ± 0.0 d | 0.0 ± 0.0 b | 0.0 ± 0.0 d |
| FOC | 3.4 ± 0.6 d | 4.0± 1.0 b | 4.6 ± 1.5 b | 7.4 ± 1.5 a | 10.6 ± 1.5 a | 64.8 ± 6.0 a |
| SGFP1 | 13.2 ± 0.6 b | 10.6 ± 0.5 a | 4.0 ± 0.0 c | 2.2 ± 0.4 c | 0.0 ± 0.0 b | 21.0 ± 1.3 c |
| SGFP2 | 10.6 ± 0.5 c | 9.4 ± 0.6 a | 5.4 ± 0.6 a | 4.6 ± 0.6 b | 0.0 ± 0.0 b | 28.3 ± 2.2 b |
| Treatment | Biomass (g/Seedling) | Height (cm) | Stem Diameter (mm) | Leaf Area (cm2) | Chlorophyll Content (mg/g) | |
|---|---|---|---|---|---|---|
| Fresh Weight | Dry Weight | |||||
| Cont | 3.9 ± 0.7 b | 0.36 ± 0.1 c | 19.1 ± 0.7 b | 4.2 ± 0.2 b | 54.6 ± 2.9 c | 0.9 ± 0.1 b |
| FOC | 2.4 ± 0.6 c | 0.2 ± 0.1 d | 8.9 ± 1.3 c | 3.8 ± 0.4 b | 34.8 ± 3.9 d | 0.8 ± 0.1 b |
| SGFP1 | 5.2 ± 0.3 a | 0.6 ± 0.1 a | 28.6 ± 2.9 a | 4.9 ± 0.3 a | 78.3 ± 4.3 a | 1.3 ± 0.3 a |
| SGFP2 | 4.9 ± 0.4 a | 0.5 ± 0.1 b | 25.1 ± 2.1 a | 4.3 ± 0.2 ab | 62.4 ± 1.8 b | 1.2 ± 0.2 a |
| Treatment | Biomass (g/Seedling) | Root Activity mg/(g·h) | |
|---|---|---|---|
| Fresh Weight | Dry Weight | ||
| Cont | 0.6 ± 0.1 a | 136.7 ± 10.6 b | 0.4 ± 0.1 c |
| FOC | 0.3 ± 0.1 b | 67.9 ± 5.7 c | 0.2 ± 0.1 d |
| SGFP1 | 0.7 ± 0.3 a | 157.2 ± 9.7 a | 0.7 ± 0.1 a |
| SGFP2 | 0.6 ± 0.2 a | 120.6 ± 8.6 b | 0.6 ± 0.1 b |
Disclaimer/Publisher’s Note: The statements, opinions and data contained in all publications are solely those of the individual author(s) and contributor(s) and not of MDPI and/or the editor(s). MDPI and/or the editor(s) disclaim responsibility for any injury to people or property resulting from any ideas, methods, instructions or products referred to in the content. |
© 2024 by the authors. Licensee MDPI, Basel, Switzerland. This article is an open access article distributed under the terms and conditions of the Creative Commons Attribution (CC BY) license (https://creativecommons.org/licenses/by/4.0/).
Share and Cite
Zhu, C.; Li, X.; Gao, Y.; Yang, X.; Gao, Y.; Li, K. Potential of Streptomyces rochei G-6 for Biocontrol of Cucumber Wilt Disease and Growth Enhancement. J. Fungi 2024, 10, 885. https://doi.org/10.3390/jof10120885
Zhu C, Li X, Gao Y, Yang X, Gao Y, Li K. Potential of Streptomyces rochei G-6 for Biocontrol of Cucumber Wilt Disease and Growth Enhancement. Journal of Fungi. 2024; 10(12):885. https://doi.org/10.3390/jof10120885
Chicago/Turabian StyleZhu, Chengyu, Xin Li, Yan Gao, Xueying Yang, Yuliang Gao, and Kuihua Li. 2024. "Potential of Streptomyces rochei G-6 for Biocontrol of Cucumber Wilt Disease and Growth Enhancement" Journal of Fungi 10, no. 12: 885. https://doi.org/10.3390/jof10120885
APA StyleZhu, C., Li, X., Gao, Y., Yang, X., Gao, Y., & Li, K. (2024). Potential of Streptomyces rochei G-6 for Biocontrol of Cucumber Wilt Disease and Growth Enhancement. Journal of Fungi, 10(12), 885. https://doi.org/10.3390/jof10120885






